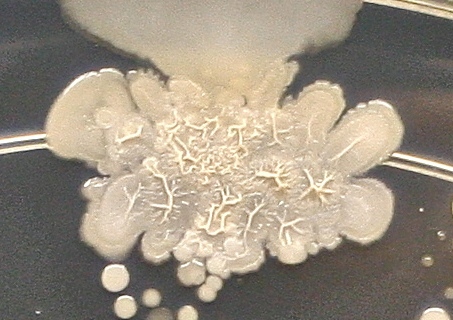

Acest vas Petri este plin de bacterii şi de fungi pe care ea le-a găsit pe mâna fiului său în vârstă de 8 ani, după ce băieţelul s-a jucat pe afară.
Click pentru a mări
FOTO: Tash Strum/microbeworld.org
Sturm a folosit pentru acest experiment un agar triptic de soia care formează un jeleu plin cu nutrienţi perfect pentru creşterea culturilor microbiene. Fiul ei a apăsat cu mâna pe acel gel din vasul Petri, iar femeia a incubat cultura şi a lăsat bacteriile să se dezvolte în voie timp de câteva zile, scrie Bored Panda.

FOTO: Tash Strum/microbeworld.org
În imaginile surprinse ulterior de Tash Strum sunt vizibile diferite structuri formate de colonii de bacterii. Acestea reflectă caracteristicile lor microscopice. Există astfel microbi cu sau fără membrane protectoare sau flageli – elemente care le permit să se deplaseze, care au format colonii de diferite culori, forme, texturi şi dimensiuni.
FOTO: Tash Strum/microbeworld.org
Este normal să avem în viaţa de zi cu zi bacterii pe piele. Expunerea la cantităţi sigure şi la diferite tipuri de bacterii asigură dezvoltarea unui sistem imunitar sănătos şi o cultură bună de bacterii în tractul digestiv.

FOTO: Tash Strum/microbeworld.org